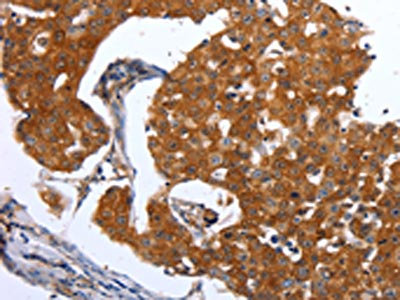

-
中文名稱:MAP2K1兔多克隆抗體
-
貨號:CSB-PA439945
-
規格:¥1100
-
圖片:
-
The image on the left is immunohistochemistry of paraffin-embedded Human breast cancer tissue using CSB-PA439945(MAP2K1 Antibody) at dilution 1/25, on the right is treated with synthetic peptide. (Original magnification: ×200)
-
The image on the left is immunohistochemistry of paraffin-embedded Human ovarian cancer tissue using CSB-PA439945(MAP2K1 Antibody) at dilution 1/25, on the right is treated with synthetic peptide. (Original magnification: ×200)
-
Gel: 10%SDS-PAGE, Lysate: 40 μg, Lane: Mouse brain tissue, Primary antibody: CSB-PA439945(MAP2K1 Antibody) at dilution 1/450, Secondary antibody: Goat anti rabbit IgG at 1/8000 dilution, Exposure time: 1 minute
-
-
其他:
產品詳情
-
Uniprot No.:
-
基因名:
-
別名:Dual specificity mitogen activated protein kinase kinase 1 antibody; Dual specificity mitogen-activated protein kinase kinase 1 antibody; ERK activator kinase 1 antibody; MAP kinase kinase 1 antibody; MAP kinase/Erk kinase 1 antibody; MAP2K1 antibody; MAPK/ERK kinase 1 antibody; MAPKK 1 antibody; MAPKK1 antibody; MEK 1 antibody; Mek1 antibody; MEKK1 antibody; Mitogen activated protein kinase kinase 1 antibody; MKK 1 antibody; MKK1 antibody; MP2K1_HUMAN antibody; PRKMK1 antibody; Protein kinase mitogen activated kinase 1 (MAP kinase kinase 1) antibody; Protein kinase mitogen activated, kinase 1 antibody; protein kinase mitogen-activated kinase 1 antibody
-
宿主:Rabbit
-
反應種屬:Human,Mouse,Rat
-
免疫原:Synthetic peptide of Human MAP2K1
-
免疫原種屬:Homo sapiens (Human)
-
標記方式:Non-conjugated
-
抗體亞型:IgG
-
純化方式:Antigen affinity purification
-
濃度:It differs from different batches. Please contact us to confirm it.
-
保存緩沖液:-20°C, pH7.4 PBS, 0.05% NaN3, 40% Glycerol
-
產品提供形式:Liquid
-
應用范圍:ELISA,WB,IHC
-
推薦稀釋比:
Application Recommended Dilution ELISA 1:1000-1:5000 WB 1:200-1:1000 IHC 1:25-1:100 -
Protocols:
-
儲存條件:Upon receipt, store at -20°C or -80°C. Avoid repeated freeze.
-
貨期:Basically, we can dispatch the products out in 1-3 working days after receiving your orders. Delivery time maybe differs from different purchasing way or location, please kindly consult your local distributors for specific delivery time.
-
用途:For Research Use Only. Not for use in diagnostic or therapeutic procedures.
相關產品
靶點詳情
-
功能:Dual specificity protein kinase which acts as an essential component of the MAP kinase signal transduction pathway. Binding of extracellular ligands such as growth factors, cytokines and hormones to their cell-surface receptors activates RAS and this initiates RAF1 activation. RAF1 then further activates the dual-specificity protein kinases MAP2K1/MEK1 and MAP2K2/MEK2. Both MAP2K1/MEK1 and MAP2K2/MEK2 function specifically in the MAPK/ERK cascade, and catalyze the concomitant phosphorylation of a threonine and a tyrosine residue in a Thr-Glu-Tyr sequence located in the extracellular signal-regulated kinases MAPK3/ERK1 and MAPK1/ERK2, leading to their activation and further transduction of the signal within the MAPK/ERK cascade. Activates BRAF in a KSR1 or KSR2-dependent manner; by binding to KSR1 or KSR2 releases the inhibitory intramolecular interaction between KSR1 or KSR2 protein kinase and N-terminal domains which promotes KSR1 or KSR2-BRAF dimerization and BRAF activation. Depending on the cellular context, this pathway mediates diverse biological functions such as cell growth, adhesion, survival and differentiation, predominantly through the regulation of transcription, metabolism and cytoskeletal rearrangements. One target of the MAPK/ERK cascade is peroxisome proliferator-activated receptor gamma (PPARG), a nuclear receptor that promotes differentiation and apoptosis. MAP2K1/MEK1 has been shown to export PPARG from the nucleus. The MAPK/ERK cascade is also involved in the regulation of endosomal dynamics, including lysosome processing and endosome cycling through the perinuclear recycling compartment (PNRC), as well as in the fragmentation of the Golgi apparatus during mitosis.
-
基因功能參考文獻:
- Upregulation of miR101 inhibited DLBCL cell proliferation and facilitated apoptosis by inhibiting the expression of MEK1. PMID: 30365139
- Somatic activating mutations in MAP2K1 cause melorheostosis. PMID: 29643386
- Here the authors identified a direct interaction of both MEK1 and MEK2 with AKT. The interaction between MEK and AKT affects cell migration and adhesion, but not proliferation. The specific mechanism of action of the MEK-AKT complex involves phosphorylation of the migration-related transcription factor FoxO1. PMID: 28225038
- Activating mutations enhance the rate of MEK1 phosphorylation by Raf. Activating mutations affect thermal stability of MEK1 and its activity toward ERK2. PMID: 29018093
- Data indicate two atypical hairy cell leukemia (HCLc)- and hairy cell leukemia variant (HCLv)-like cases with clinically detected mitogen-activated protein kinase kinase 1 (MAP2K1) mutations. PMID: 27241017
- Reactive oxygen species-mediated EGFR/MEK/ERK/HIF-1A loop regulates glucose metabolism in pancreatic cancer. PMID: 29702094
- High MEK1 expression is associated with urinary bladder cancer metastasis. PMID: 28534984
- we detected mutually exclusive KRAS and MAP2K1 mutations in one-third of cases of Rosai-Dorfman disease PMID: 28664935
- The rs1549854 and rs1432441 polymorphisms of the MAP2K1 gene may be associated with major depressive disorder, especially in females. PMID: 28688265
- MEK1 does not act as a general tumor suppressor in leukemogenesis. Rather, its effects strongly depend on the genetic context (RAS versus MYC-driven leukemia) and on the cell type involved. PMID: 27741509
- Report a synthetic lethal interaction of cetuximab in combination with MEK1/2 inhibition for the NRAS mutant subgroup of metastatic colorectal cancer. PMID: 27636997
- High MEK1 expression is associated with liver cancer. PMID: 26967560
- The BRAF/MAP2K1-mut LCH cells had a more immature state than BRAF/MAP2K1-wt LCH cells. Authors also found the BRAFV600E and MAP2K1 mutations were significantly associated with pERK expression. PMID: 27597420
- There are no other biomarkers correlated with treatment responses following MEK1/2 inhibition. PMID: 27956260
- High MEK1 expression is associated with neuroblastoma. PMID: 28687621
- mutations in MAP2K1, which are frequently associated with neurological complications and intellectual disability, can be associated with a milder clinical and neurocognitive profile more typical of individuals with Noonan syndrome. Variability of expression may arise from a complex interplay between RAS/MAPK pathway genotype, epigenetics, medical and obstetric factors, and environmental influences. PMID: 27862862
- High MEK1 expression is associated with infant acute lymphoblastic leukemia. PMID: 27588400
- Data show that combined therapy using HER2 inhibitor and BRAF/MEK inhibitor presented more significant redifferentiation effect on papillary thyroid cancer cells harboring BRAFV600E than BRAF/MEK inhibitor alone. PMID: 28423638
- MEK1 is constitutively and mainly phosphorylated at the Thr-292, Ser-298, Thr-386, and Thr-388 residues in vivo, and combinations of phosphorylations at these four residues produce at least six phosphorylated variants of MEK1. The phosphorylation statuses of Thr-292, Ser-298, Thr-386, and Thr-388 residues vary widely during activation and deactivation of the MAPK pathway. PMID: 27169363
- TNFRSF14 and MAP2K1 mutations are the most frequent genetic alterations found in pediatric-type follicular lymphoma (PTFL) and occur independently in most cases, suggesting that both mutations might play an important role in PTFL lymphomagenesis. PMID: 28533310
- There was no statistically significant association between BRAF or MAP2K1 mutation and anatomic site, unifocal versus multifocal presentation, or clinical outcome in Langerhans cell histiocytosis. PMID: 26980021
- High MEK1 expression is associated with inflammation. PMID: 28178421
- Lgr4 is a critical positive factor for skin tumorigenesis by mediating the activation of MEK1/ERK1/2 and Wnt/beta-catenin pathways. PMID: 27693558
- somatic mutations in MAP2K1 are a common cause of extracranial arteriovenous malformation PMID: 28190454
- MEK1 mutation is associated with central nervous system metastases of non-small cell lung cancer. PMID: 26860843
- The MAP2K1 mutation analysis of three hairy cell leukemia cases, one hairy cell leukemia-variant case, and three splenic marginal zone lymphoma cases revealed negative results. PMID: 25729732
- Data show that mitogen-activated protein kinase kinases MEK1/2 inhibitor pimasertib (MEKI) sensitized the cells to apoptosis through its ability to promote a G1 cell cycle arrest. PMID: 26625317
- Specific inhibition of BRAF oncogene, MEK or p38 signaling was associated with decreases in DIO3 expression in papillary thyroid cancer cells PMID: 26825960
- Data show that Ba/F3 cells transformed with mutant HRAS protien indicated equal sensitivity towards Map kinase kinase (MEK) and mTOR serine-threonine kinase (mTOR) inhibition. PMID: 26544513
- Our data demonstrate that MEK inhibitors can inhibit breast cancer stem cells and may have clinical potential for the prevention of metastasis in certain cases in which tumors are MAPK dependent. PMID: 26384399
- Data show that src kinases (SRC) and mitogen-activated protein kinase kinase 1 (MEK) co-inhibition by saracatinib and PD0325901 respectively can be broadly effective in tumor growth control of a wide panel of non-small cell lung cancer (NSCLC) cell lines. PMID: 26358373
- at clinically relevant concentrations, cDDP binds to and inhibits MEK1/2 and both the binding and inhibitory activity are related to its interaction with Cu bound to MEK1/2 PMID: 26155939
- Studies indicate that concurrent inhibition of proto-oncogene protein B-raf (BRAF) and Map kinase kinase (MEK) improved the most effective therapeutic modality as compared as single BRAF or MEK inhibition for patients with metastatic melanoma (MM). PMID: 26143635
- Findings suggest that triple therapy directed against BRAF/MEK/ErbB3 may be able to provide durable control of BRAF mutated metastatic melanoma. PMID: 26208478
- MEK1 levels are upregulated at transcriptional level whereas MEK2 levels are downregulated at posttranslational level. PMID: 26163823
- NOTCH1, TP53, and MAP2K1 mutations in splenic diffuse red pulp small B-cell lymphoma are associated with progressive disease. PMID: 26426381
- MEK1/2 inhibitor trametinib showed similar PFS and a response rate as docetaxel in patients with previously treated KRAS-mutant-positive non-small cell lung carcinoma. PMID: 25722381
- Findings establish that the convergence of 2 distinct Ras effector pathways on mammalian target of rapamycin signaling maintains neurofibromatosis type 1 mouse optic glioma growth. PMID: 25534823
- MEK1 Mutations are associated with Low-grade Serous Ovarian Cancer. PMID: 26324360
- SGK1 inhibits intestinal epithelial cell apoptosis and promotes proliferation via the MEK/ERK/p53 pathway in colitis. PMID: 26034353
- MEK1 mutations define a distinct subset of lung cancers ( approximately 1%) with potential sensitivity to MEK inhibitors. Mutations are predominantly transversions, in keeping with a strong association with smoking. PMID: 25351745
- Data show that licochalcone A (LicoA) suppresses solar UV-induced cyclooxygenase (COX-2) expression by acting as a potent inhibitor of enzymes PI3K, MEK1, and B-Raf. PMID: 25710724
- Langerhans cell histiocytosis cells can harbor additional genetic alterations in the RAS-RAF-MEK pathway which, in the case of MAP2K1, may be responsible for ERK activation in a wild type BRAF setting. PMID: 25899310
- our data indicate that preexisting MEK1(P124) mutations are associated with a reduced response to BRAF inhibitor therapy and identify a subset of patients with BRAF-mutant melanoma likely to benefit from combination therapies PMID: 25370473
- MAP2K1 missense mutations were found in 2 of 11 patients with cadiofaciocutaneous syndrome: Pro124Gln and Asp67Asn. PMID: 25194980
- We documented three novel mutations in the BRAF gene in cardio-facio-cutaneous syndrome patients and correlated clinical findings with causative mutations in the BRAF or MEK1/MEK2 genes PMID: 25463315
- MEK1 is associated with carboplatin resistance and is a prognostic biomarker in epithelial ovarian cancer. PMID: 25408231
- Treatment of cells with sirtuin inhibitors, or siRNA knockdown of SIRT1 or SIRT2 proteins, increases MEK1 acetylation and subsequent phosphorylation of the extracellular signal-regulated kinase. PMID: 24681949
- MEK1/2 inhibitor potentiated the anti-tumor effects of cisplatin in KRAS-dependent lung cancer cells and an animal model through inhibition of BIM degradation PMID: 25541062
- Findings support the hypothesis that BDNF and MEK1 mRNA expression levels are more obviously decreased in patients with treatment-resistant depression. PMID: 24709918
顯示更多
收起更多
-
相關疾病:Cardiofaciocutaneous syndrome 3 (CFC3)
-
亞細胞定位:Cytoplasm, cytoskeleton, microtubule organizing center, centrosome. Cytoplasm, cytoskeleton, microtubule organizing center, spindle pole body. Cytoplasm. Nucleus. Membrane; Peripheral membrane protein.
-
蛋白家族:Protein kinase superfamily, STE Ser/Thr protein kinase family, MAP kinase kinase subfamily
-
組織特異性:Widely expressed, with extremely low levels in brain.
-
數據庫鏈接:
Most popular with customers
-
YWHAB Recombinant Monoclonal Antibody
Applications: ELISA, WB, IHC, IF, FC
Species Reactivity: Human, Mouse, Rat
-
Phospho-YAP1 (S127) Recombinant Monoclonal Antibody
Applications: ELISA, WB, IHC
Species Reactivity: Human
-
-
-
-
-
-